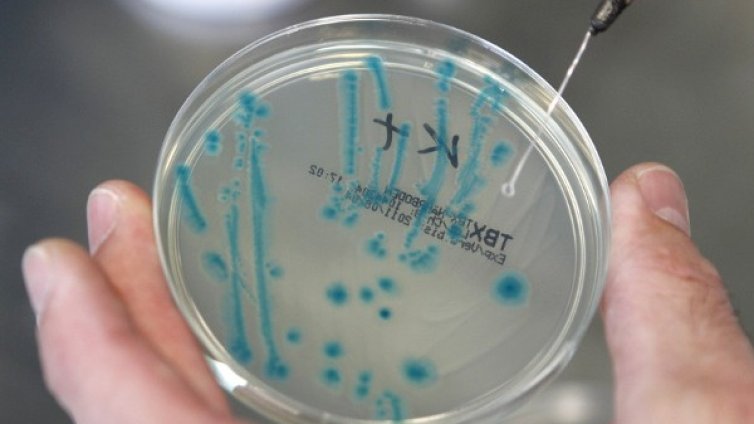
Нов щам на свинския грип

Новини
-
След пороите: Издирват 55-годишен мъж в Севлиево
-
Прическата на Деми Мур предизвика фурор на филмовия фестивал в Кан
-
Гечев от ПБ: Не искаме да правим регулации, искаме ясно ценообразуване
-
Кои бяха най-добре облечените звезди на дефилето на Louis Vuitton
-
Иван Христанов за цените: Германия има 7% ДДС, ние имаме 20%
-
Коя е прическата, за която Дженифър Анистън винаги съжалява, макар Сандра Бълок да смята, че ѝ отива
-
БАБХ спря 1800 кг храни след проверки в четири магазина в София
-
Радев: Да се разплетат случаите с Пепи Еврото и Нотариуса, Путин не е капитулирал
-
Има ли прикрито убийство по време на дежурство във военно поделение в Костенец?
-
Моментът на истината за Путин: да сложи край на войната или да прегърне сталинизма
-
Белезниците щракнаха: Прокурорският син Васил Михайлов е заловен
-
Тръмп публикува нови НЛО-файлове, сред тях и смразяващ аудиозапис от екипажа на Аполо 12 ВИДЕО
-
Евакуация и в Севлиево, водата по улиците достигна 1,20 метра
-
Който контролира Мала Токмачка, контролира света: Как битката за украинско село се превърна в мемe
-
Пролетна буря 2026: Обучение на прага на Русия, НАТО се готви за бойно поле, управлявано от дронове
-
Радев: Да се разплетат случаите с Пепи Еврото и Нотариуса, Путин не е капитулирал
-
Моментът на истината за Путин: да сложи край на войната или да прегърне сталинизма
-
Наводнени къщи, отнесени автомобили и павета: Ситуацията във Велико Търново е критична
-
Търсят се 160 000 сезонни работници у нас, спешно наемат чужденци
-
Който контролира Мала Токмачка, контролира света: Как битката за украинско село се превърна в мемe
-
Bangaranga е положението: Песента е на гръцки продуцент, такава е сделката

"Орешник" изглежда пак пропусна, но Киев преживява масирана ракетна атака
"Орешник" изглежда пак пропусна, но Киев преживява масирана ракетна атака  Украйна се готви за нападение с "Орешник", ООН настоява за достъп до Старобилск
Украйна се готви за нападение с "Орешник", ООН настоява за достъп до Старобилск  Марк Рубио: Постигнат е напредък в преговорите с Иран
Марк Рубио: Постигнат е напредък в преговорите с Иран  Uber предлага да придобие Delivery Hero срещу 33 евро на акция
Uber предлага да придобие Delivery Hero срещу 33 евро на акция  САЩ доставиха на Полша първите три самолета F-35 от общата поръчка за 32 машини
САЩ доставиха на Полша първите три самолета F-35 от общата поръчка за 32 машини  България и Азербайджан планират ускоряване на проекта за „Зелен енергиен коридор“
България и Азербайджан планират ускоряване на проекта за „Зелен енергиен коридор“ 
 Тръмп: Иран е много по-близо до споразумение за войната
Тръмп: Иран е много по-близо до споразумение за войната  Христанов: Държавата ограбва собствения си народ
Христанов: Държавата ограбва собствения си народ  4 зодии ще имат късмет в любовта и парите на 24 май
4 зодии ще имат късмет в любовта и парите на 24 май  Гечев: Цените ще паднат с регулации и значително производство
Гечев: Цените ще паднат с регулации и значително производство  "Селтик" победи "Дънфърмлин" с 3:1 за Купата на Шотландия
"Селтик" победи "Дънфърмлин" с 3:1 за Купата на Шотландия  Блясък и звезди на закриването на 79-ия филмов фестивал в Кан (СНИМКИ)
Блясък и звезди на закриването на 79-ия филмов фестивал в Кан (СНИМКИ) 
 Торино – Ювентус
Торино – Ювентус  Милан – Каляри
Милан – Каляри  Спортът по телевизията днес, 24 май
Спортът по телевизията днес, 24 май  Мачовете по телевизията днес, 24 май
Мачовете по телевизията днес, 24 май  Валенсия обърна Барса, Лева се сбогува с гол
Валенсия обърна Барса, Лева се сбогува с гол  Реал Мадрид завърши с победа, Мбапе стана голмайстор на Ла Лига
Реал Мадрид завърши с победа, Мбапе стана голмайстор на Ла Лига 
 Седмична таро прогноза за 25 – 31 май 2026
Седмична таро прогноза за 25 – 31 май 2026  Дневен хороскоп за 24 май, неделя
Дневен хороскоп за 24 май, неделя  Седмична нумерологична прогноза за 25 – 31 май
Седмична нумерологична прогноза за 25 – 31 май  10 празнични рецепти за 24 май
10 празнични рецепти за 24 май  Маникюри за пари и късмет през юни (+Снимки)
Маникюри за пари и късмет през юни (+Снимки)  Любовен хороскоп за 25 – 31 май
Любовен хороскоп за 25 – 31 май 
 продава, Тристаен апартамент, 104 m2 Пловдив, Мараша, 195000 EUR
продава, Тристаен апартамент, 104 m2 Пловдив, Мараша, 195000 EUR  продава, Двустаен апартамент, 80 m2 Бургас, Сарафово, 129500 EUR
продава, Двустаен апартамент, 80 m2 Бургас, Сарафово, 129500 EUR  продава, Едностаен апартамент, 40 m2 Велико Търново, Бузлуджа, 74000 EUR
продава, Едностаен апартамент, 40 m2 Велико Търново, Бузлуджа, 74000 EUR  продава, Едностаен апартамент, 40 m2 Бургас област, с.Равда, 62000 EUR
продава, Едностаен апартамент, 40 m2 Бургас област, с.Равда, 62000 EUR  продава, Едностаен апартамент, 32 m2 Бургас област, гр.Свети Влас, 60000 EUR
продава, Едностаен апартамент, 32 m2 Бургас област, гр.Свети Влас, 60000 EUR  продава, Тристаен апартамент, 91 m2 Бургас област, с.Равда, 117000 EUR
продава, Тристаен апартамент, 91 m2 Бургас област, с.Равда, 117000 EUR 
 Черно море Тича загуби първия мач за бронза
Черно море Тича загуби първия мач за бронза  Правителството на Радев планира да изтегли дълг от 3.8 млрд. евро
Правителството на Радев планира да изтегли дълг от 3.8 млрд. евро  Назначиха Кристиян Колев за съдия на мача Черно море - Арда
Назначиха Кристиян Колев за съдия на мача Черно море - Арда  Седмичен хороскоп 25 - 31 май 2026
Седмичен хороскоп 25 - 31 май 2026  Обявиха номинациите за театралните награди "Аскеер" 2026
Обявиха номинациите за театралните награди "Аскеер" 2026  Мъж подкара лодка по улиците на Севлиево (ВИДЕО)
Мъж подкара лодка по улиците на Севлиево (ВИДЕО) 
 Учени откриха най-стария лед на Земята: Защо беше важно да го намерят?
Учени откриха най-стария лед на Земята: Защо беше важно да го намерят?  SpaceX изстреля за първи път новата версия на Starship (снимки)
SpaceX изстреля за първи път новата версия на Starship (снимки)  Заради боклука в Космоса: Япония пуска нова версия на своя дървен сателит
Заради боклука в Космоса: Япония пуска нова версия на своя дървен сателит  По-големите награди драстично ускоряват ученето в мозъка
По-големите награди драстично ускоряват ученето в мозъка  Бъдещите колонисти на Марс ще могат да си принтират инструменти на място
Бъдещите колонисти на Марс ще могат да си принтират инструменти на място  НАСА изпрати първия имейл от най-мощния космически процесор в историята
НАСА изпрати първия имейл от най-мощния космически процесор в историята